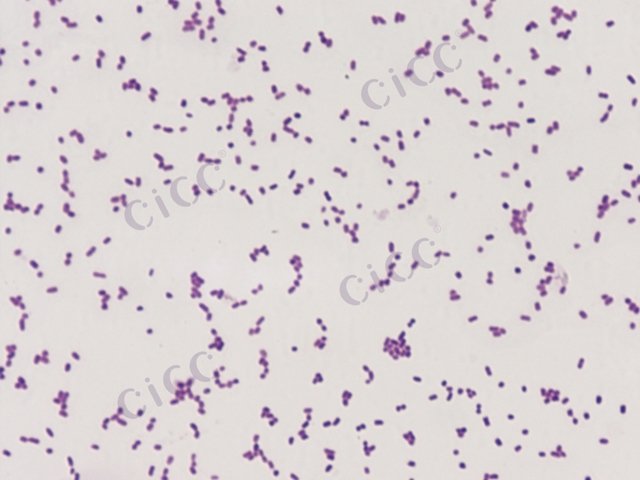
Salmonella enterica subsp enterica serotype Wandsworth

Salmonella enterica subsp enterica serotype Wandsworth
-
Salmonella enterica subsp enterica serotype Wandsworth
CICC 21616 | 见证书
-
Salmonella enterica subsp enterica serotype Wandsworth
CICC 21504 | 见证书
-
Salmonella enterica subsp enterica serotype Jerusalem
CICC 21651 | 见证书
-
Salmonella enterica subsp enterica serotype Bonn
CICC 21677 | 见证书
-
Salmonella enterica subsp. enterica serotype Abony
BNCC360775 | 冻干粉;斜面;菌液;平板
-
Salmonella enterica subsp enterica serotype Bonariensis
CICC 21496 | 见证书
-
Salmonella enterica subsp enterica serotype Dakar
CICC 21507 | 见证书

说明书下载: 菌种说明书 打管说明书
您正在浏览的产品:肠沙门氏菌肠亚种旺兹沃思血清型 Salmonella enterica subsp enterica serotype Wandsworth CICC 21498
手机版:肠沙门氏菌肠亚种旺兹沃思血清型 Salmonella enterica subsp enterica serotype Wandsworth CICC 21498
本公司销售的所有产品仅供实验科研使用,不用于人体及临床诊断。